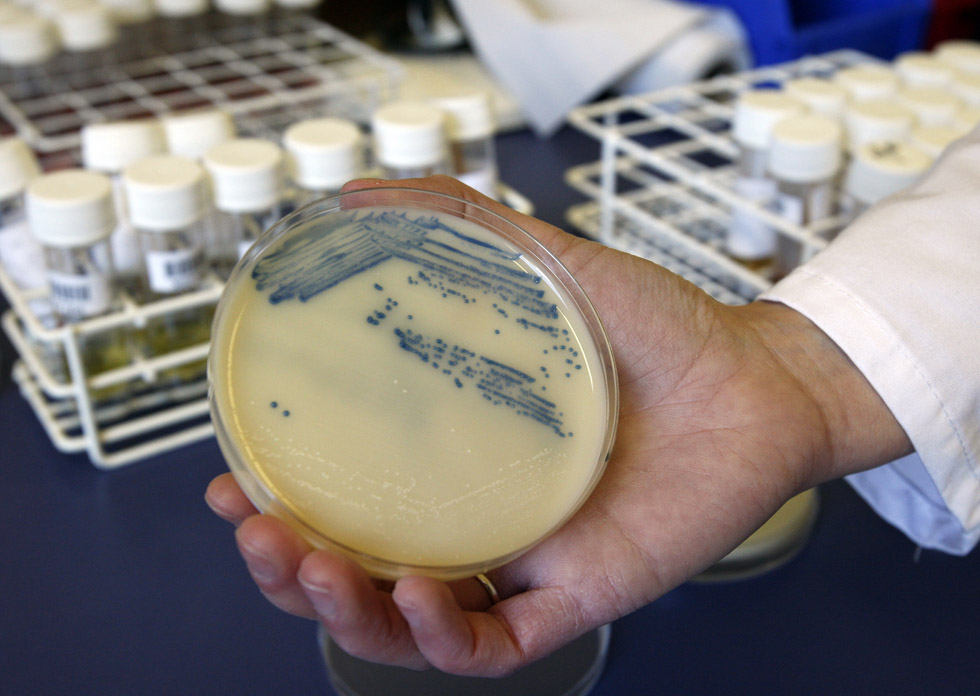
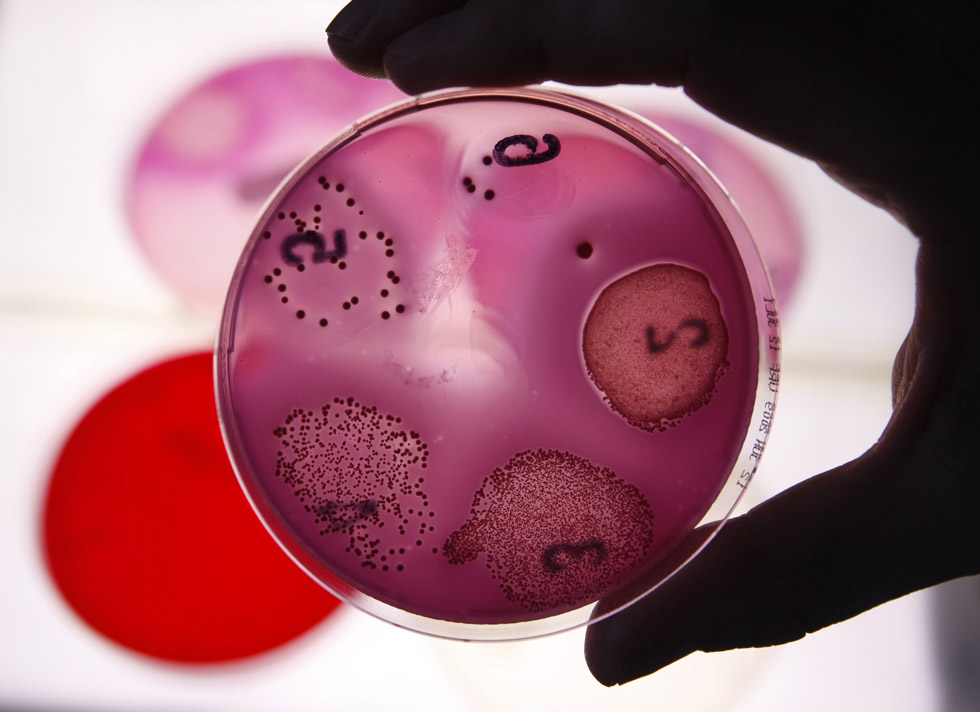
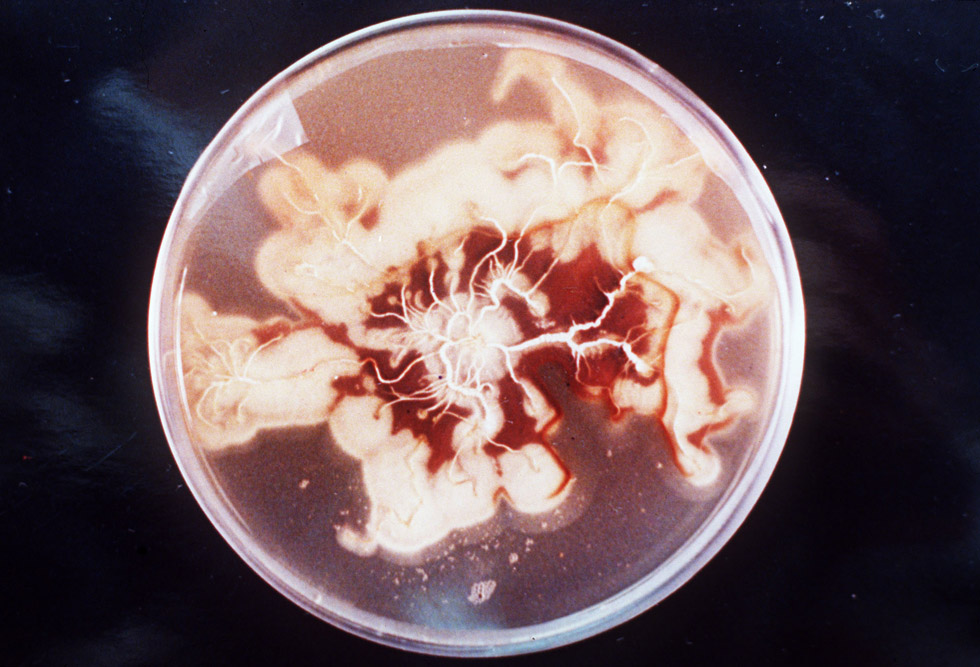
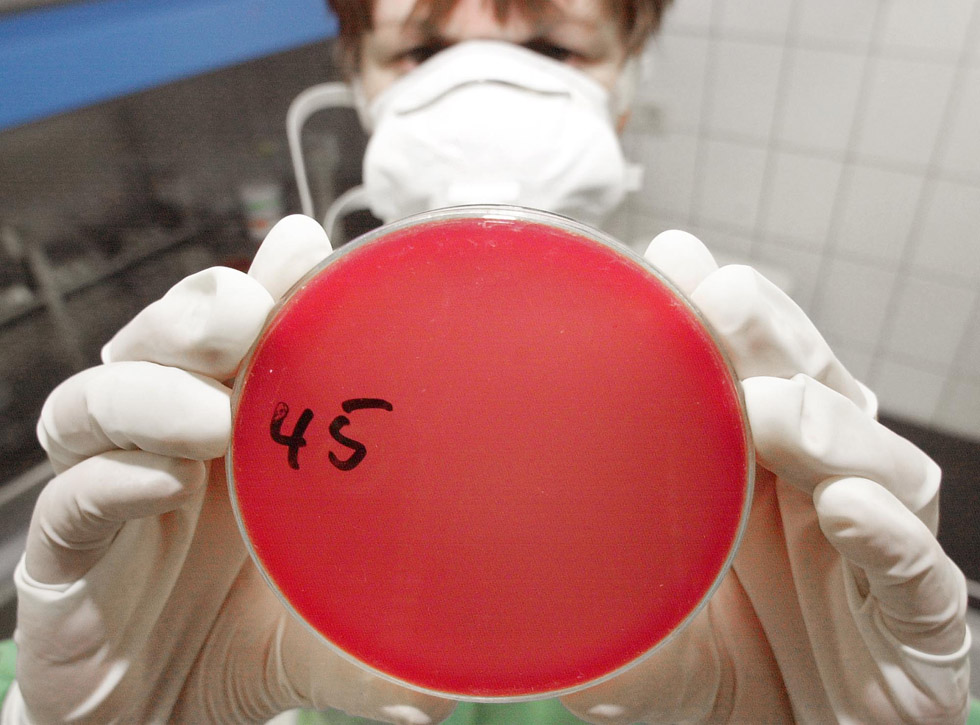
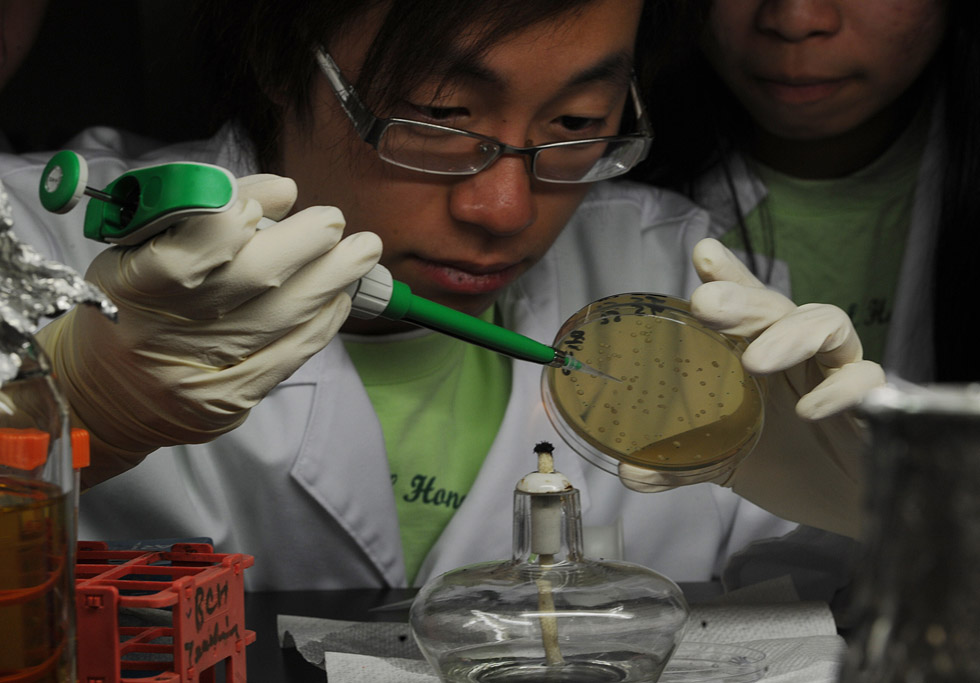

1 di 15
Julius Richard Petri e le sue piastre
Alcuni embrioni di bovino su una piastra di Petri, durante una serie di studi sulla clonazione nel giugno del 2001 alla Università della Georgia di Athens, negli Stati Uniti
(Erik S. Lesser/Getty Images)

Alcuni embrioni di bovino su una piastra di Petri, durante una serie di studi sulla clonazione nel giugno del 2001 alla Università della Georgia di Athens, negli Stati Uniti
(Erik S. Lesser/Getty Images)

Uno studio sulle zanzare su una piastra di Petri realizzato a Portland, nel Maine, l'8 settembre del 2010
(AP Photo/Pat Wellenbach)
Una piastra di Petri con una coltura di Staphylococcus aureus resistente alla meticillina realizzata presso il Queen Elizabeth Hospital di King Lynn nel Regno Unito, nell'ottobre del 2009, nell'ambito di una sperimentazione per ridurre alcuni casi di infezione da stafilococco
(AP Photo/Kirsty Wigglesworth)

Una piastra di Petri per lo studio di alcuni insetti all'Università della California di Riverside, negli Stati Uniti, nel marzo del 2009
(AP Photo/Damian Dovarganes)
Lo studio di alcuni enterobatteri in un laboratorio di Stoccarda nel luglio del 2009, effettuato su una piastra di Petri
(AP Photo/Thomas Kienzle)

Una piastra di petri con alcuni campioni di nematodi, vermi cilindrici, durante alcune verifiche sanitarie in laboratorio in seguito al loro ritrovamento in una tanica al Kennedy Space Center di Cape Canaveral in Florida, nel maggio del 2003
(AP Photo/NASA)
Lo studio di un campione di un enorme fungo scoperto in un'ampia porzione di territorio del Michigan, Stati Uniti
(AP-PHOTO/MTU-HO)

Campioni di vongola dalla proboscide (Panopea abrupta) in una piastra di Petri presso il laboratorio Qutekcak Shellfish Hatchery di Seward in Alaska, nel dicembre del 2011
(AP Photo/Seward Phoenix LOG, Nancy Erickson)
Un ricercatore controlla una piastra di Petri in un laboratorio a Erfurt, nell'est della Germania, nel 2001: contiene un campione di una sostanza sospetta trovata in una lettera
(AP Photo/Jens Meyer)
La preparazione di una piastra di Petri all'Università della Cina di Hong Kong per lo studio di alcune caratteristiche delle colonie di batteri E. coli, nel dicembre del 2010
(MIKE CLARKE/AFP/Getty Images)

Un ricercatore controlla una piastra di Petri nell'ambito di uno studio su alcune specie di pesci nella provincia del Qinghai in Cina, nel 2005
(China Photos/Getty Images)

Alcune lucciole disposte su una piastra di Petri a Baltimora, Maryland, nella seconda metà degli anni Cinquanta
(Orlando /Three Lions/Getty Images)

Piastre di Petri in un laboratorio durante alcuni studi sulla penicillina nel 1954
(Keystone Features/Getty Images)

Alcuni studi in laboratorio su piastre di Petri nel maggio del 1946
(Douglas Miller/Keystone Features/Getty Images)

La ricercatrice Lindasy Webb nel suo laboratorio a Concord nel New Hampshire, insieme con le sue piastre di Petri per gli studi su alcune farfalle a rischio di estinzione. 23 marzo 2011
(AP Photo/Jim Cole)